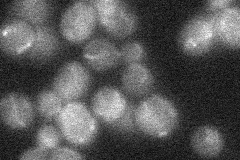
YCR106W
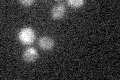
YCR106W

View description
Zinc cluster transcription factor involved in conferring resistance to cycloheximide
Localization:
Intensity:
Fold change:
Significance:
-
C’ GFP library in SD

cytosol18.82 -
N' NOP1pr-GFP in SD

punctate,nucleus50.7995 -
N' TEF2pr-mCherry in SD

punctate,nucleus49.9235 -
N' NATIVEpr-GFP in SD
below threshold14.9735 -
N' TEF2pr-VC and Cyto-VN in SD

punctate32.0539 -
C’ GFP library in SD+DTT

cytosol18.630.98No -
C’ GFP library in SD+H2O2

cytosol18.760.99No -
C’ GFP library in Starvation Media
cytosol15.530.82No -
C’ GFP library on the background of Pup2-DaMP

cytosol -
C’ GFP library on the background of CCT mutant

cytosolN/AN/ANo
